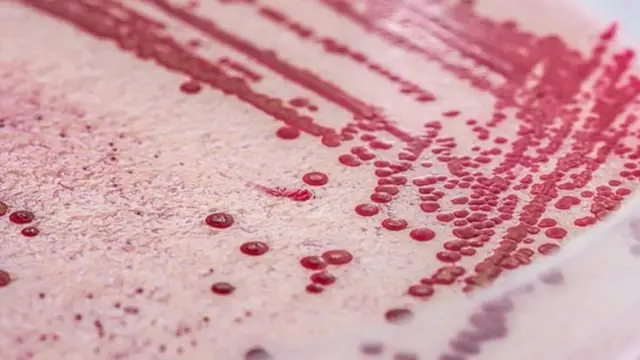
لستيريا

وفاة ثلاثة بسبب التسمم من البطيخ الأبيض في استراليا

صدر الصورة، Getty Images
لقى ثلاثة أشخاص مصرعهم في استراليا وأصيب 15 جراء تناول شمام أصفر ملوث ببكتيريا لستيريا.
وتبين أن جميع الإصابات من كبار السن وجاءت جراء تناول الشمام، المعروف في بعض دول الشرق الأوسط بالبطيخ الأبيض بالكنتالوب، الذي تبين أنه كان مزروعا في مقاطعة نيو ساوث ويلز.
وتوفيت أول حالتين في نيو ساوث ويلز، بينما كانت الضحية الثالثة من مقاطعة فيكتوريا.
وأصدرت السلطات الاسترالية تحذيرا لكبار السن والأطفال والنساء الحوامل بضرورة تجنب تناول الشمام الأصفر المقطع إلى شرائح.
وبينت التحقيقات أن جميع المصابين بالعدوى تناولوا الكنتالوب قبل أن تظهر عليهم أعراض المرض.
وقالت فيكي شيبرد، مدير قسم الأمراض المعدية في هيئة الصحة بنيوساوث ويلز :"الأشخاص المعرضون للخطر يجب عليهم التخلص من أي كنتالوب اشتروه قبل الأول من مارس/آذار".
وتتبعت السلطات الكنتالوب الملوث والعدوى المتفشية وتبين أن مصدره مزرعة بالقرب من مدينة غريفيث في نيو ساوث ويلز.
وتم سحب الكنتالوب من الأسواق في جميع أنحاء استراليا بعد اكتشاف تفشي العدوى، والتي ظهرت لأول مرة منذ يناير/كانون ثاني الماضي.
صدر الصورة، Getty Images
ما هي بكتيريا لستيريا؟
يصاب الإنسان بهذه العدوى عند تناول طعاما ملوثا ببتكتيريا لستيريا أو كان قريبا جدا من حيوانات المزرعة.
عادة ما تشمل مصادر الإصابة الحليب غير المبستر أو منتجات الألبان، مثل جبن الكامامبير الفرنسي الطري، والجبن الأبيض.
كما توجد بكتيريا لستيريا أيضا في الطعام غير المعلب مثل الساندوتشات والمخبوزات.
وتظهر أعراض الإصابة في شكل ارتفاع في درجات الحرارة وظهور أعراض الإصابة بالإنفلونزا، وكذلك حدوث القيء والجفاف.
قد لا تظهر الأعراض على غالبية المصابين بالعدوى، لكن كبار السن والصغار يكونوا أكثر عرضة للخطر، بالإضافة إلى أصحاب المناعة الضعيفة.



























